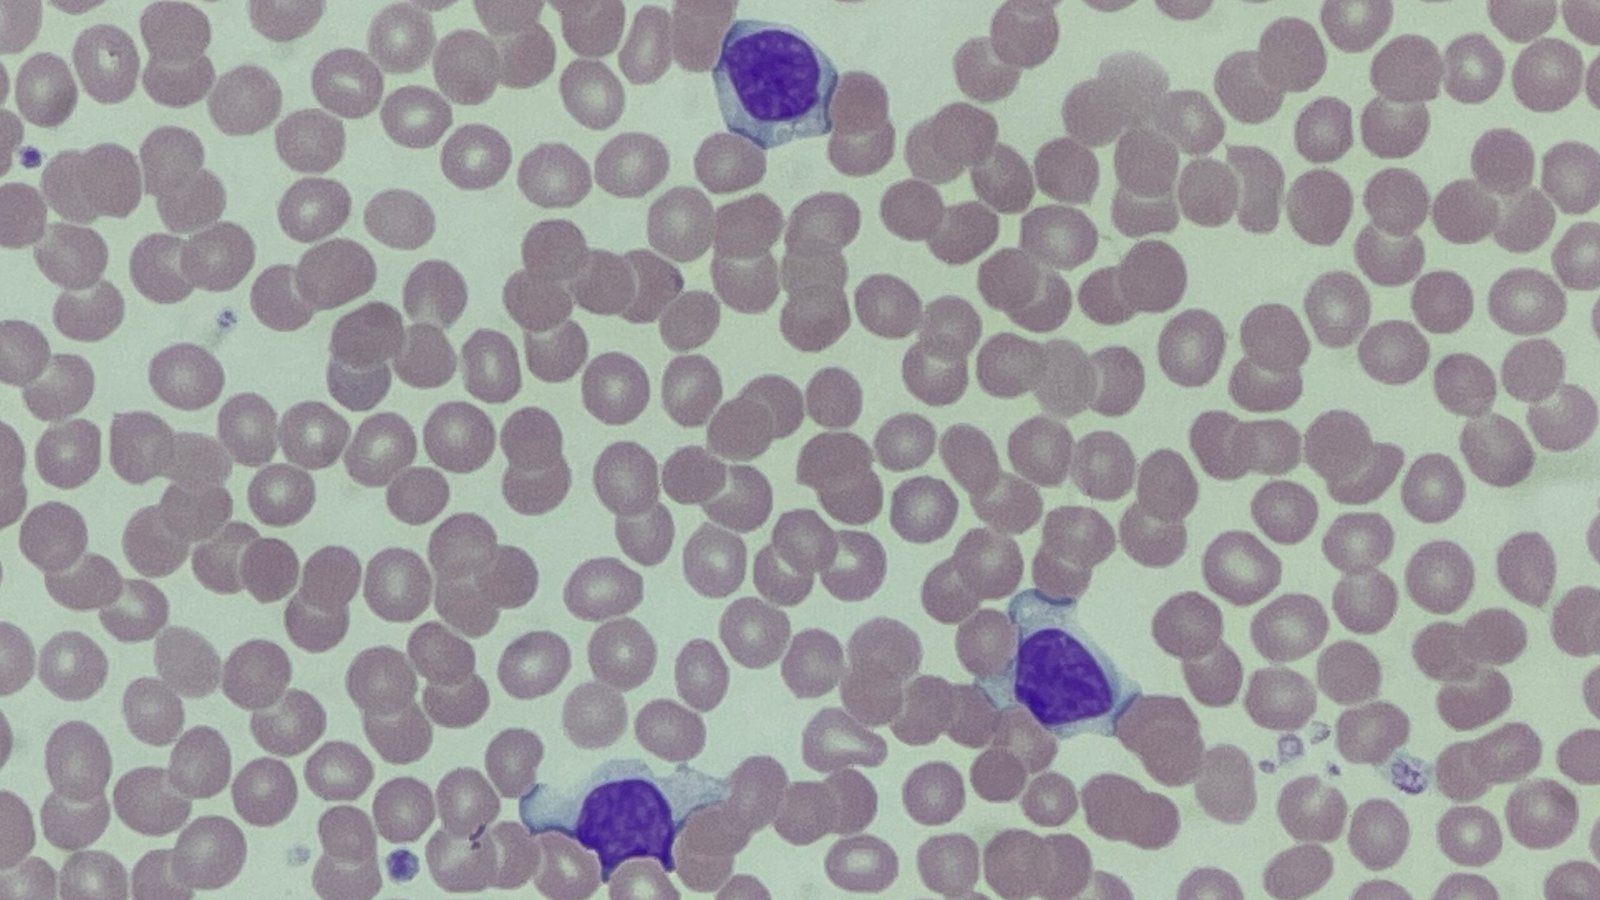
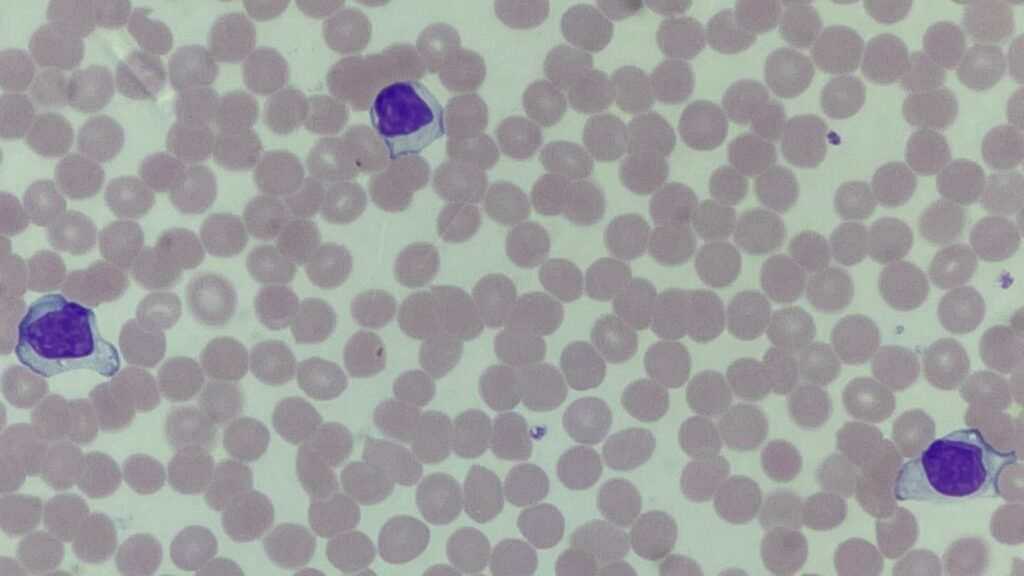

In our recent Morphology Monday case, a man in his 20s presented with 7 days of malaise and cervical lymphadenopathy. His blood film showed classic reactive lymphocytes — and a positive Monospot test confirmed the diagnosis of infectious mononucleosis.
Infectious mononucleosis (IM), also known as glandular fever, is a common clinical presentation in adolescents and young adults, often caused by the Epstein-Barr virus (EBV). It typically presents with fever, malaise, sore throat, and lymphadenopathy — and often ends up in the lab when these symptoms don’t resolve. Investigations include a full blood count, peripheral blood film and the monospot (Paul Bunnell) test.

One of the hallmark findings on the blood film in IM is the presence of atypical lymphocytes, also referred to as Downey cells after haematologist Hal Downey. These reactive T cells are a hallmark of EBV infection and show exaggerated basophilic cytoplasm that scallops around surrounding red cells, giving them a distinctive, “hugging” appearance. Recognising these cells in the right clinical context can be a powerful diagnostic clue.

The Monospot test, also known as the Paul-Bunnell test, is a heterophile antibody test commonly used to support the diagnosis of infectious mononucleosis. A positive result typically indicates a current or recent Epstein-Barr virus (EBV) infection. However, the test has limitations as it can be negative in the early stages of illness and may produce false positives in the presence of other viral infections.
2 Comments
Good to know as clinically is difficult to differentiate from leukemias.The picture provided here is with great insight and explanation.
Thanks